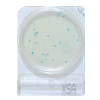

Productos
Contenido del equipo
- Contenedor de Hisopos
- Caja de 100 pzas.
- Presentación de 5 paquetes
- Cada paquete contiene 20 pzas
Aplicaciones
- En superficies vivas (manos del personal)
- En superficies inertes como: equipos mesas, tanques, cuchillos , tablas, etc.
- En fluidos (agua de enjuague)

Sistema Compac Dry
Sistema Compac Dry Luminometro PD-20
Luminometro PD-20 Lucypac Pen
Lucypac Pen


